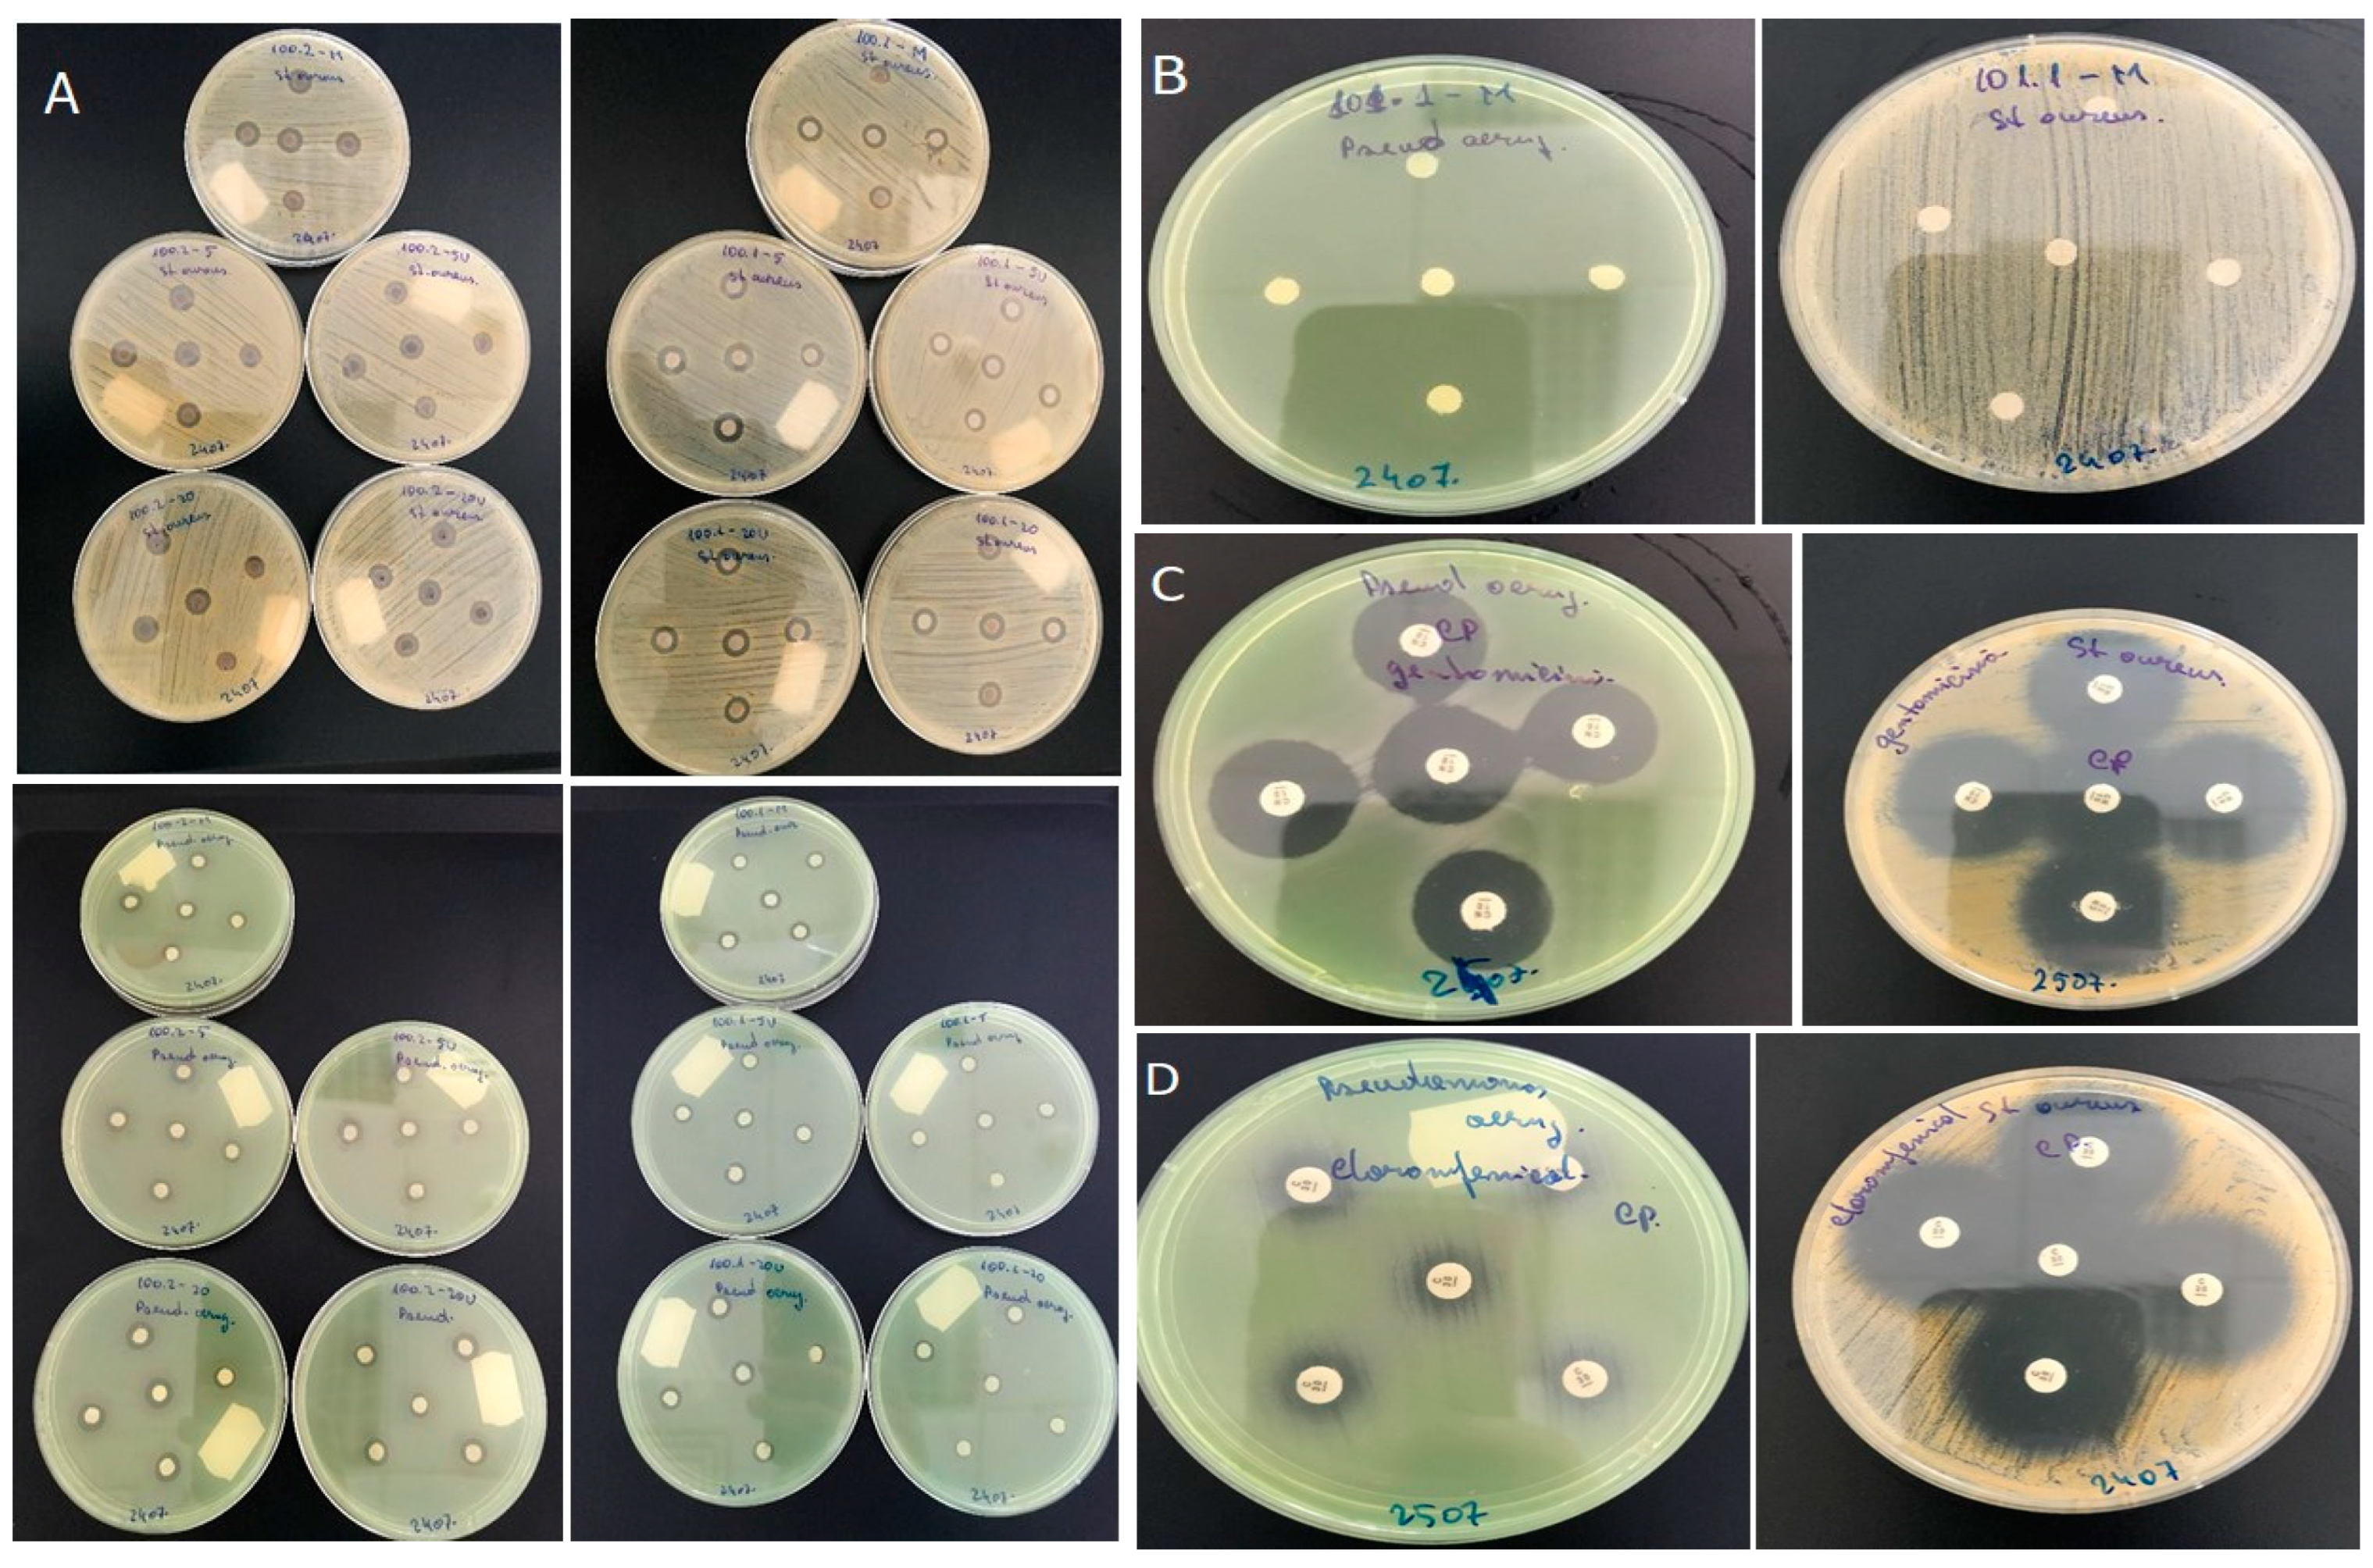

Gamma Irradiation and Ag and ZnO Nanoparticles Combined Treatment of Cotton Textile Materials
Abstract
:1. Introduction
2. Materials and Methods
2.1. Silver and ZnO Nanoparticles Preparation
2.1.1. Ag Nanoparticles Were Prepared by Two Different Methods, Using Chitosan and PVP, Respectively
2.1.2. Zinc Oxide Nanoparticles Preparation
2.2. Textile Materials Treatment
Gamma Irradiation
2.3. Materials Characterization
3. Results and Discussion
3.1. FTIR-ATR Analysis
3.2. TG/DTG Analysis
3.3. Antimicrobial Testing
4. Conclusions
Supplementary Materials
Author Contributions
Funding
Institutional Review Board Statement
Informed Consent Statement
Data Availability Statement
Conflicts of Interest
References
- Mostafalu, P.; Kiaee, G.; Giatsidis, G.; Khalilpour, A.; Nabavinia, M.; Dokmeci, M.R.; Sonkusale, S.; Orgill, D.P.; Tamayol, A.; Khademhosseini, A. A textile dressing for temporal and dosage-controlled drug delivery. Adv. Funct. Mater. 2017, 27, 1702399. [Google Scholar] [CrossRef]
- Schmidt, A.; Paul, R.; Classen, E.; Morlock, S.; Beringer, J. 2 comfort testing and fit analysis of military textiles. In Performance Testing of Textiles, Woodhead Publishing Series in Textiles; Wang, L., Ed.; Woodhead Publishing: Amsterdam, The Netherlands, 2016; pp. 25–37. [Google Scholar] [CrossRef]
- Carey, T.; Cacovich, S.; Divitini, G.; Ren, J.; Mansouri, A.; Kim, J.M.; Wang, C.; Ducati, C.; Sordan, R.; Torrisi, F. Fully inkjet-printed two-dimensional material field-effect heterojunctions for wearable and textile electronics. Nat. Commun. 2017, 8, 1–11. [Google Scholar] [CrossRef] [PubMed] [Green Version]
- Mahmud, R.; Nabi, F. Application of nanotechnology in the field of textile. IOSR J. Polym. Text. Eng. 2017, 4, 2181p–2348p. [Google Scholar] [CrossRef]
- Mashitah, M.D.; Chan, Y.S.; Jaison, J. Antimicrobial properties of nanobiomaterials and the mechanism. In Nanobiomaterials in Antimicrobial Therapy, Applications of Nanobiomaterials; William Andrew Publishing, Elsevier: Amsterdam, The Netherlands, 2016; pp. 261–312. [Google Scholar]
- Zheng, K.; Setyawati, M.I.; Leong, D.T.; Xie, J. Antimicrobial silver nanomaterials. Coord. Chem. Rev. 2018, 357, 1–17. [Google Scholar] [CrossRef]
- Guzmán, M.G.; Dille, J.; Godet, S. Synthesis of silver nanoparticles by chemical reduction method and their antibacterial activity. Int. J. Chem. Biomol. Eng. 2009, 2, 104–111. [Google Scholar]
- Durán, N.; Nakazato, G.; Seabra, A.B. Antimicrobial activity of bio-genic silver nanoparticles, and silver chloride nanoparticles: An over-view and comments. Appl. Microbiol. Biotechnol. 2016, 100, 6555–6570. [Google Scholar] [CrossRef]
- Sheikh, N.; Akhavan, A.; Kassaee, M.Z. Synthesis of antibacterial silver nanoparticles by γ-irradiation. Radiat. Phys. Chem. 2009, 42, 132–135. [Google Scholar] [CrossRef]
- Landolt, A.M.; Lomax, N. Gamma knife radiosurgery for prolactinomas. J. Neurosurg. 2000, 93 (Suppl. 3), 14–18. [Google Scholar] [CrossRef]
- Chirila, L.; Popescu, A.; Cutrubinis, M.; Stanculescu, I.; Moise, V.I. The influence of gamma irradiation on natural dyeing properties of cotton and flax fabrics. Radiat. Phys. Chem. 2018, 145, 97–103. [Google Scholar] [CrossRef]
- Wang, J.-P.; Chen, Y.-Z.; Zhang, S.-J.; Yu, H.-Q. A chitosan-based flocculant prepared with gamma-irradiation-induced grafting. Bioresour. Technol. 2008, 99, 3397–3402. [Google Scholar] [CrossRef]
- Moise, V.; Stanculescu, I.; Vasilca, S.; Cutrubinis, M.; Pincu, E.; Oancea, P.; Raducan, A.; Meltzer, V. Consolidation of very degraded cultural heritage wood artefacts using radiation curing of polyester 180 resins. Radiat. Phys. Chem. 2019, 156, 314–319. [Google Scholar] [CrossRef]
- Geba, M.; Lisa, G.; Ursescu, C.M.; Olaru, A.; Spiridon, I.; Leon, A.L.; Stanculescu, I. Gamma irradiation of protein-based textiles for historical collections decontamination. J. Therm. Anal. Calorim. 2014, 118, 977–985. [Google Scholar] [CrossRef]
- Inshakova, E.; Inshakov, O. World market for nanomaterials: Structure and 185 trends. MATEC Web Conf. 2017, 129, 02013. [Google Scholar] [CrossRef]
- Eby, D.M.; Luckarift, H.R.; Johnson, G.R. Hybrid antimicrobial enzyme and silver nanoparticle coatings for medical instruments. ACS Appl. Mater. Interfaces 2009, 1, 1553–1560. [Google Scholar] [CrossRef]
- Kalishwaralal, K.; Luboshits, G.; Firer, M.A. Synthesis of Gold Nanoparticle: Peptide–Drug Conjugates for Targeted Drug Delivery; Springer: New York, NY, USA, 2020; pp. 145–154. [Google Scholar] [CrossRef]
- Huang, D.; Liao, F.; Molesa, S.; Redinger, D.; Subramanian, V. Plasticcompatible low resistance printable gold nanoparticle conductors for flexible electronics. J. Electrochem. Soc. 2003, 150, G412. [Google Scholar] [CrossRef] [Green Version]
- Chirila, L.; Radulescu, D.E.; Cinteza, L.O.; Radulescu, D.M.; Tanase, M.; Stanculescu, I.R. Hybrid materials based on ZnO and SiO2 nanoparticles as hydrophobic coatings for textiles. Ind. Text. 2020, 71, 297–301. [Google Scholar] [CrossRef]
- Hanh, T.T.; Van Phu, D.; Thu, N.T.; Hien, N.Q. Gamma irradiation of cotton fabrics in AgNO3 solution for preparation of antibacterial fabrics. Carb. Polym. 2014, 101, 1243–1248. [Google Scholar] [CrossRef]
- Available online: https://www.sciencedirect.com/topics/engineering/textile-finishing (accessed on 23 February 2022).
- Gilbert, C.; Kokot, S.; Meyer, U. Application of DRIFT Spectroscopy and Chemometrics for the Comparison of Cotton Fabrics. Appl. Spectrosc. 1993, 47, 741–748. [Google Scholar] [CrossRef]
- Chung, C.; Lee, M.; Choe, E.K. Characterization of cotton fabric scouring by FT-IR ATR spectroscopy. Carbohydr. Polym. 2004, 58, 417–420. [Google Scholar] [CrossRef]
- Siriviriyanun, A.; O’Rear, E.; Yanumet, N. Self-Extinguishing Cotton Fabric with Minimal phosphorous deposition. Cellulose 2008, 15, 731–737. [Google Scholar] [CrossRef]
- Alongi, J.; Colleoni, C.; Rosace, G.; Malucelli, G. Phosphorus- and nitrogen-doped silica coatings for enhancing the flame retardancy of cotton: Synergisms or additive effects? Polym. Degrad. Stab. 2013, 98, 579–589. [Google Scholar] [CrossRef]

| Experimental FTIR-ATR (cm−1) | Literature (cm−1) | Vibration Mode |
|---|---|---|
| 3550–3100 | 3570–3200 | H-bonded OH stretch |
| 2980–2800 | 3000–2800 | CH stretch |
| 2850 | 2849 | Symmetric CH2 stretch; long alkyl chain |
| 1642 | 1650–1633 | H2O adsorbed |
| 1428 | 1430 | CH wagging in plane bending |
| 1368 | 1372 | CH bending deformation stretch |
| 1335 | 1336 | OH in plane bending |
| 1314 | 1320 | CH wagging |
| 1280 | 1282 | CH deformation stretch |
| 1247 | 1236 | OH in plane bending |
| 1204 | 1204 | OH in plane bending |
| 1161 | 1178 | Asymmetric bridge COC |
| 1108 | 1130 | Asymmetric bridge COC |
| 1054 | 1092 | Asymmetric in plane ring stretch |
| 1030 | 1042 | CO stretch |
| 1001 | 998–1002 | CO stretch |
| 898 | 898 | Asym. out of phase ring stretch C1OC4; β glycosidic bond |
| Treatment | 5 kGy Irradiation in a Dry State | 5 kGy Irradiation in a Wet State | ||
|---|---|---|---|---|
| Decomposition Peak | Residual Mass | Decomposition Peak | Residual Mass | |
| Ag/C | 366.4 °C 27.18%/min | 6.13% | 364.0 °C 27.97%/min | 8.86% |
| Ag/PVP | 340.0 °C 20.93%/min | 14.68% | 337.6 °C 20.28%/min | 14% |
| ZnO/PVP | 360.0 °C 33.50%/min | 6.71% | 358.1 °C 32.30%/min | 11.95% |
Publisher’s Note: MDPI stays neutral with regard to jurisdictional claims in published maps and institutional affiliations. |
© 2022 by the authors. Licensee MDPI, Basel, Switzerland. This article is an open access article distributed under the terms and conditions of the Creative Commons Attribution (CC BY) license (https://creativecommons.org/licenses/by/4.0/).
Share and Cite
Capraru, O.-A.; Lungu, B.; Virgolici, M.; Constantin, M.; Cutrubinis, M.; Chirila, L.; Cinteza, L.O.; Stanculescu, I. Gamma Irradiation and Ag and ZnO Nanoparticles Combined Treatment of Cotton Textile Materials. Materials 2022, 15, 2734. https://doi.org/10.3390/ma15082734
Capraru O-A, Lungu B, Virgolici M, Constantin M, Cutrubinis M, Chirila L, Cinteza LO, Stanculescu I. Gamma Irradiation and Ag and ZnO Nanoparticles Combined Treatment of Cotton Textile Materials. Materials. 2022; 15(8):2734. https://doi.org/10.3390/ma15082734
Chicago/Turabian StyleCapraru, Ovidiu-Alexandru, Bogdan Lungu, Marian Virgolici, Mihai Constantin, Mihalis Cutrubinis, Laura Chirila, Ludmila Otilia Cinteza, and Ioana Stanculescu. 2022. "Gamma Irradiation and Ag and ZnO Nanoparticles Combined Treatment of Cotton Textile Materials" Materials 15, no. 8: 2734. https://doi.org/10.3390/ma15082734
APA StyleCapraru, O.-A., Lungu, B., Virgolici, M., Constantin, M., Cutrubinis, M., Chirila, L., Cinteza, L. O., & Stanculescu, I. (2022). Gamma Irradiation and Ag and ZnO Nanoparticles Combined Treatment of Cotton Textile Materials. Materials, 15(8), 2734. https://doi.org/10.3390/ma15082734

